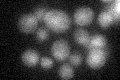
YER173W
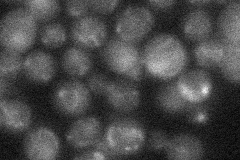
YER173W
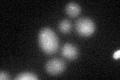
YER173W

View description
Checkpoint protein, involved in the activation of the DNA damage and meiotic pachytene checkpoints; subunit of a clamp loader that loads Rad17p-Mec3p-Ddc1p onto DNA; homolog of human and S. pombe Rad17 protein
Localization:
Intensity:
Fold change:
Significance:
-
C’ GFP library in SD
nucleus18.54 -
N' NOP1pr-GFP in SD

nucleus42.1257 -
N' TEF2pr-mCherry in SD

missing0 -
N' NATIVEpr-GFP in SD
cytosol21.7744 -
N' TEF2pr-VC and Cyto-VN in SD

#N/A0 -
C’ GFP library in SD+DTT
nucleus20.031.08No -
C’ GFP library in SD+H2O2

nucleus21.561.16No -
C’ GFP library in Starvation Media

nucleus16.990.91No -
C’ GFP library on the background of Pup2-DaMP

nucleus -
C’ GFP library on the background of CCT mutant

nucleus19.98171.07709No
